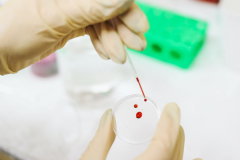

生活科普:貓咪得了「異食癖」,罐罐都不香了!
生活科普:貓咪得了「異食癖」,罐罐都不香了!
北京科學(xué)中心
02-28
2023

生活科普:用嘴呼吸真的會(huì)讓顏值崩塌嗎?
生活科普:用嘴呼吸真的會(huì)讓顏值崩塌嗎?
科學(xué)辟謠
02-27
2023

生活科普:連煮咖啡都和數(shù)學(xué)有關(guān)系?
學(xué)渣:有被冒犯到!
科普中國
02-24
2023

生活科普:沒冰箱,古人怎么給食品防腐?他們想了7個(gè)辦法
生活科普:沒冰箱,古人怎么給食品防腐?他們想了7個(gè)辦法
北京科協(xié)
02-24
2023

生活科普:燒焦的食物會(huì)致癌?做飯?zhí)崆白龅竭@4點(diǎn),不再“談焦色變”!
生活科普:燒焦的食物會(huì)致癌?做飯?zhí)崆白龅竭@4點(diǎn),不再“談焦色變”!
科普中國
02-24
2023

生活科普:白色草莓是轉(zhuǎn)基因水果嗎?
生活科普:白色草莓是轉(zhuǎn)基因水果嗎?
科學(xué)辟謠
02-24
2023

健康科普:出現(xiàn)這5種情況,說明你的免疫力出問題了!
5個(gè)方法幫你增強(qiáng)免疫力
CCTV生活圈
02-24
2023

生活科普:你知道茶、咖啡、油、水也會(huì)讓人“醉”嗎?
生活科普:你知道茶、咖啡、油、水也會(huì)讓人“醉”嗎?
新華網(wǎng)
02-24
2023

自然科普:你敢信?疫苗注射這件事兒上,蚊子竟然能幫上忙!
自然科普:你敢信?疫苗注射這件事兒上,蚊子竟然能幫上忙!
科普中國
02-23
2023
生活科普:有血緣關(guān)系,就能做親子鑒定嗎?還真不一定.......
生活科普:有血緣關(guān)系,就能做親子鑒定嗎?還真不一定.......
北京科學(xué)中心
02-23
2023
 會(huì)員登錄
會(huì)員登錄



















